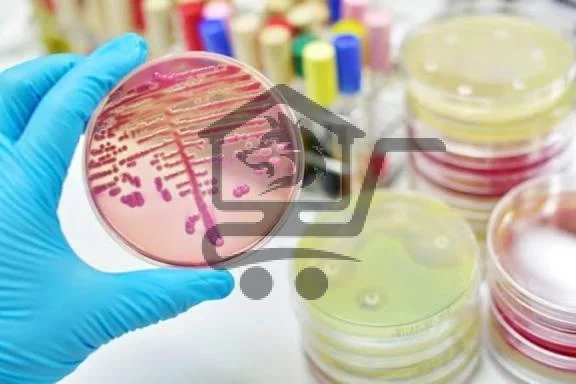
عيادة د. ميس حوّاط  أخصائية أمراض باطنة مُعدية (إن - الصورة 3

جاري تحميل الإعلانات...
5
12
عيادة د. ميس حوّاط أخصائية أمراض باطنة...

 إعلان
إعلان
 اللاذقية
> اللاذقية
> حي الدعتور
اللاذقية
> اللاذقية
> حي الدعتور
منذ شهرين
































 اختر التصنيف
اختر التصنيف
 البحث الجغرافي
البحث الجغرافي